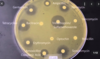

Fundamental of Pharmacology Flashcards
(181 cards)
What are the 5 ways a cell can communicate with other cells?
1 - endocrine (in the blood, long distance)
2 - paracrine (close cells)
3 - juxtacrine (cells touching or via membrane rceptors)
4 - autocrine (cells signals itself)
5 - neuronal
In GPCRs, what determines its intracellular activity, for example, is the GPCR turned on or off?
- GTP = GPCR on
- GDP = GPCR off
Of the four intracellular signalling below, which has the quickest reaction?
1 - GPCR
2 - Iontrophic receptors (ion or ligand gated)
3 - Kinase linked receptors
4 - cytoplasmic/nuclear receptor
- iontrophic receptors (ion or ligand gated)
- almost immediate
In order rank the the four intracellular signalling below from quickest to slowest reaction?
1 - GPCR
2 - Iontrophic receptors (ion or ligand gated)
3 - Kinase linked receptors
4 - cytoplasmic/nuclear receptor
1 - Iontrophic receptors (ion or ligand gated)
2 - GPCRs
3 - kinase linked receptors
4 - cytoplasmic/nuclear receptor
If a drug is being developed that will decrease cAMP levels, which GPCR will this be?
- Gai
What is the definition of a side effect?
- undesirable secondary effect in addition to the desired therapeutic effect
- dose of drug is normal dose
What is the definition of an adverse effect?
- harmful effect on a patient
- dose of drug is normal dose
What is the definition of an adverse effect?
- deleterious, undesired effect
- dose of drug is higher than normal dose
What is the difference between allosteric and orthosteric binding sites?
- orthosteric = active site
- allosteric = non active site, but binding changes conformation so orthosteric site can not be accessed
When something binds to a receptor but the normal physiological or regulatory effect, what is this called?
- antagonist
If something is able to bind to the allosteric site of a receoptor and does not have the same regulatory effect, what is this called in terms of pharmacodynamics?
- non competitive antagonist
What is the difference between a competitive and non-competitive antagonist in terms of pharmacology?
- competitive antagonist = competes with agonist for orthosteric (active) binding site
- non-competitive antagonist = does no competes with agonist for orthosteric (active) binding site, rather it binds to allosteric binding site causing conformational changes in receptor

Does the figure below show a competitive reversible or non-competitive reversible antagonist?

- competitive reversible
- a larger concentration (1000 vs 1) would be required to reduce effect of the agonist
Does the figure below show a competitive reversible or non-competitive reversible antagonist?

- non-competitive reversible antagonist
- a larger concentration (10 vs 1) would significantly reduce the Cmax
In terms of pharmacodynamics, what does affinity mean?
- the ability of a drug to bind with a receptor
What is efficacy in relation to pharmacotherapy?
- the ability of an agonist to produce a biological effect
What is Rmax in relation to efficacy in pharmacotherapy?
- efficacy determines how effect an agonist is at eliciting a biological effect
- Rmax = maximal response
What is potency in relation to pharmacotherapy?
- which drug has the largest effect, i.e the most potent
What is EC50 in relation to potency in pharmacotherapy?
- effective concentration to elicit a response in 50% of population taking the drug
In the figure below which drug has the highest EC50, meaning it has the highest potency in pharmacotherapy, and why is this a good thing?

- drug A
- higher potentcy means lower EC50
- lower EC50 means lower drug dose required
How do we calculate therapeutic index?
- TD50 / ED50
- TD50 = toxic dose in 50% of population using the drug
- ED50 = effetive dose in 50% of population using the drug
What are the equilibrium potentials of Na+ and K+ in the cell?
- Na+ = +60mV
- K+ = -90mV
- helps maintain restint potential
What does the resting membrane potential of a cell normally sit at?
- between -90 to -70mV
Roughly what voltage needs to be reached for an action potential to occur?
- +20 - 40mV